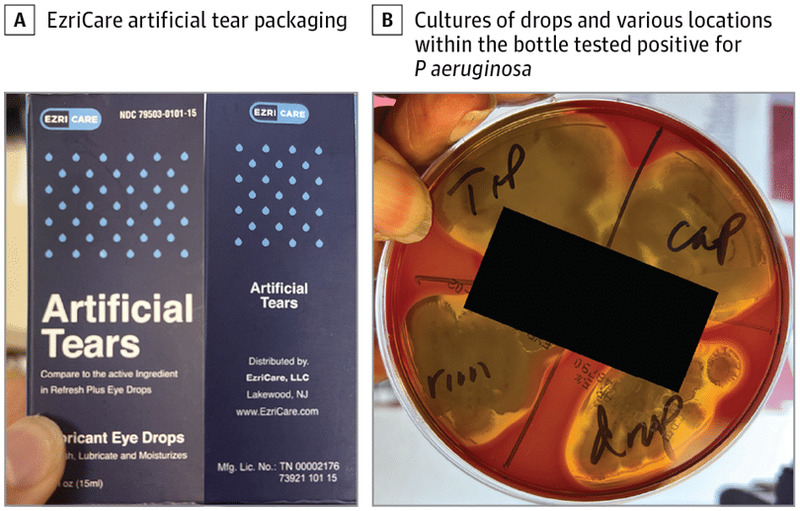
В США растет число погибших от глазных капель, зараженных синегнойной палочкой

В США растет число погибших от глазных капель, зараженных синегнойной палочкой

Центры по контролю и профилактике заболеваний США вместе с Управлением по санитарному надзору за качеством пищевых продуктов и медикаментов, а также государственными и местными департаментами здравоохранения расследуют случаи бактериальной инфекции, связанные с использованием глазных капель.
Уже три человека погибли в Соединенных Штатах Америки из-за системной бактериальной инфекции, вызванной редким и впервые выявленным в стране штаммом резистентной к антибиотикам Pseudomonas aeruginosa — синегнойной палочки. Об этом сообщается в отчете местных Центров по контролю и профилактике заболеваний (CDC).

A) Диффузная гиперемия конъюнктивы и большой центральный инфильтрат роговицы с вышележащим эпителиальным дефектом, сопровождаемый гипопионом; B) Инфильтрат роговицы оставался спустя месяц наблюдения, но консолидировался с улучшением вышележащего эпителиального дефекта и исчезновением гипопиона / © JAMA Ophthalmology
По состоянию на 21 марта в 16 штатах выявили 68 человек с бактериальным кератитом — острым воспалением роговой оболочки глаза. По предварительной и наиболее вероятной версии, большинство случаев связано с использованием глазных капель, так называемых искусственных слез. Чаще всего пациенты пользовались препаратами индийского бренда EzriCare и фирмы Delsam Pharma, базирующейся в Нью-Йорке.
Лабораторные анализы, проведенные CDC, показали наличие Pseudomonas aeruginosa во вскрытых флаконах EzriCare из нескольких партий. Капли отозвали из оборота в прошлом месяце, и медицинские власти предупредили об опасности их использования.
Симптомы заражения могут включать желтые, зеленые или прозрачные выделения из глаз; боль в глазах либо дискомфорт; покраснение глаза или века; ощущение, будто что-то попало в глаз; повышенную светочувствительность; затуманенное зрение. Врачи призвали всех соблюдать осторожность при использовании глазных капель и растворов для контактных линз.
Помимо трех летальных случаев, восемь человек ослепли, а четверым пришлось провести энуклеацию — хирургическое удаление глазного яблока. Известно, что 37 пациентов связаны с четырьмя конкретными кластерами медицинских учреждений. Также у больных встречались инфекции кровотока, дыхательных и мочевыводящих путей.
В журнале JAMA Ophthalmology вышли два (1, 2) отчета медиков из Глазного института Баскома Палмера при Университете Майами во Флориде и Университетской больницы Кливлендского медицинского центра. В первой работе подробно рассказано о 72-летнем мужчине, поступившем в больницу с болью в правом глазу и ухудшением зрения. В анамнезе у него значились ишемическая болезнь сердца, диабет и хроническая обструктивная болезнь легких. Операций на глаза не было.
Больной сообщил, что использует контактные линзы, но отрицал, что спит в них или как-либо еще злоупотребляет правилами ношения. Мужчина пользовался «искусственными слезами» EzriCare для лечения сухости глаз.
Капли EzriCare, а также крышку, ободок и кончик флакона подвергли культивированию. Все они оказались положительными на P. aeruginosa с множественной лекарственной устойчивостью / © JAMA Ophthalmology
«Внутриглазное давление было 29 миллиметров ртутного столба на правом глазу и 14 миллиметров ртутного столба на левом (норма — около 15 миллиметров ртутного столба. — Прим. ред). При осмотре у пациента выявили гиперемию конъюнктивы правого глаза, инфильтрат роговицы размером шесть на пять миллиметров с поражением вышележащего эпителия и гипопион (гнойный экссудат) в два миллиметра. Результаты УЗИ были нормальными», — сообщается в отчете.
Поскольку медик знали о предупреждении CDC по поводу использования продукции EzriCare, лечение начали с применения капель, обогащенных ванкомицином и тобрамицином, и раствора триметоприм-полимиксина каждый час во время бодрствования. Также ученые изучили образцы, взятые из инфильтрата роговицы пациента, и капли EzriCare.

Второй случай, описанный медиками: 72-летняя женщина поступила в больницу с потерей зрения на левый глаз в течение недели. Она сообщила об использовании безрецептурных глазных капель при двустороннем синдроме сухого глаза. У пациентки тоже выявили резистентную к лекарственным препаратам Pseudomonas aeruginosa, восприимчивую только к цефидероколу / © JAMA Ophthalmology
«Культура клеток роговицы была положительной на P. aeruginosa с высокой устойчивостью к таким антибиотикам, как фторхинолоны; аминогликозиды, включая амикацин и тобрамицин; и цефалоспорины, а еще с умеренной резистентностью к карбапенемам. Капли EzriCare тоже дали положительный результат на P. aeruginosa», — рассказали медики.
В итоге у пациента развились хроническая инфекция. Он продолжает лечиться под тщательным наблюдением специалистов, поскольку был риск необратимой потери зрения. Есть вероятность, что в случае трансплантации роговицы прогноз улучшится.
Кристина Прескотт, офтальмолог из Нью-Йоркского университета, призвала людей, прибегающих к глазным каплям, не прикасаться к кончику флакона руками, не делиться ими с кем-то еще и не использовать просроченные препараты. Следует соблюдать осторожность и с глазными каплями без консервантов, поскольку загрязнение может привести к тяжелой инфекции.
Comments are closed.